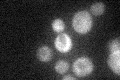
YPL119C
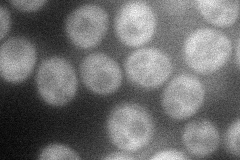
YPL119C
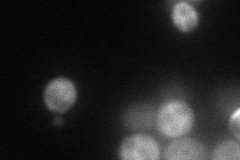
YPL119C
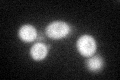
YPL119C
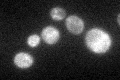
YPL119C

View description
Putative ATP-dependent RNA helicase of the DEAD-box protein family; mutants show reduced stability of the 40S ribosomal subunit scanning through 5' untranslated regions of mRNAs
Localization:
Intensity:
Fold change:
Significance:
-
C’ GFP library in SD
cytosol27.59 -
N' NOP1pr-GFP in SD
cytosol43.414 -
N' TEF2pr-mCherry in SD
cytosol66.0261 -
N' NATIVEpr-GFP in SD

missing0 -
N' TEF2pr-VC and Cyto-VN in SD

#N/A0 -
C’ GFP library in SD+DTT
cytosol29.821.08No -
C’ GFP library in SD+H2O2

cytosol27.480.99No -
C’ GFP library in Starvation Media
cytosol53.331.93Yes -
C’ GFP library on the background of Pup2-DaMP

cytosol -
C’ GFP library on the background of CCT mutant

cytosol35.86471.29968No
